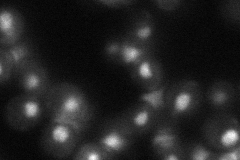
YDL002C
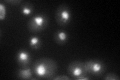
YDL002C

View description
Protein related to mammalian high mobility group proteins; binds preferentially to DNA ends and is able to protect them from exonuclease cleavage; likely component of the INO80 complex, which is an ATP-dependent chromatin-remodeling complex
Localization:
Intensity:
Fold change:
Significance:
-
C’ GFP library in SD

nucleus51.23 -
N' NOP1pr-GFP in SD

nucleus110.257 -
N' TEF2pr-mCherry in SD

missing0 -
N' NATIVEpr-GFP in SD
nucleus39.487 -
N' TEF2pr-VC and Cyto-VN in SD

#N/A0 -
C’ GFP library in SD+DTT
nucleus51.060.99No -
C’ GFP library in SD+H2O2

nucleus36.080.7No -
C’ GFP library in Starvation Media

nucleus59.691.16No -
C’ GFP library on the background of Pup2-DaMP

N/A -
C’ GFP library on the background of CCT mutant

N/A0N/AYes
